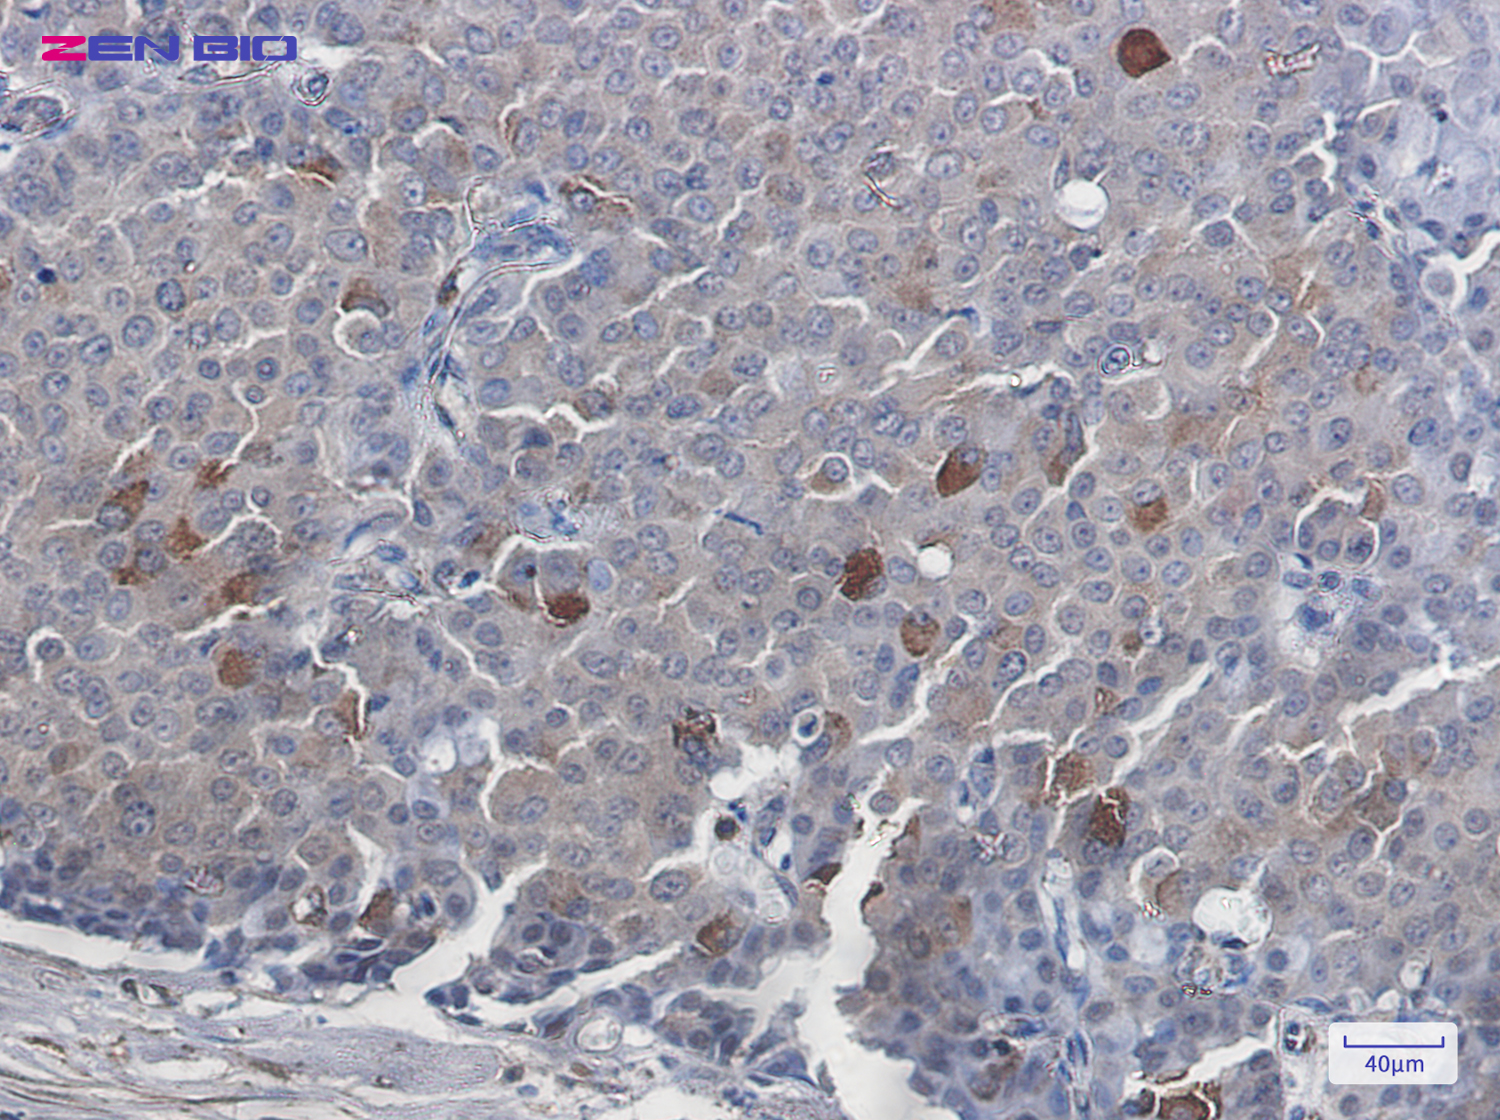

-
Product Name
Anti-EGFR Rabbit antibody
- Documents
-
Description
EGFR Rabbit polyclonal antibody
-
Tested applications
WB, IHC-P, ICC/IF, FC, IP
-
Species reactivity
Human, Mouse, Rat
-
Alternative names
ERBB; HER1; mENA; ERBB1; PIG61; NISBD2 antibody
-
Isotype
Rabbit IgG
-
Preparation
Antigen: A synthetic peptide of human EGFR
-
Clonality
Polyclonal
-
Formulation
Supplied in 50nM Tris-Glycine(pH 7.4), 0.15M Nacl, 40%Glycerol, 0.01% sodium azide and 0.05% BSA.
-
Storage instructions
Store at -20°C. Stable for 12 months from date of receipt.
-
Applications
WB: 1/1000-1/5000
IHC: 1/20-1/100
ICC/IF: 1/50
FC: 1/20-1/100
IP: 1/20
-
Validations

Western blot detection of EGFR in Hela cell lysates using EGFR Rabbit pAb(1:1000 diluted).Predicted band size:134KDa.Observed band size:175KDa.
Immunohistochemistry of EGFR in paraffin-embedded Human breast cancer tissue using EGFR Rabbit pAb at dilution 1/20
-
Background
Swiss-Prot Acc.P00533.Receptor tyrosine kinase binding ligands of the EGF family and activating several signaling cascades to convert extracellular cues into appropriate cellular responses (PubMed:2790960, PubMed:10805725, PubMed:27153536). Known ligands include EGF, TGFA/TGF-alpha, AREG, epigen/EPGN, BTC/betacellulin, epiregulin/EREG and HBEGF/heparin-binding EGF (PubMed:2790960, PubMed:7679104, PubMed:8144591, PubMed:9419975, PubMed:15611079, PubMed:12297049, PubMed:27153536, PubMed:20837704). Ligand binding triggers receptor homo- and/or heterodimerization and autophosphorylation on key cytoplasmic residues. The phosphorylated receptor recruits adapter proteins like GRB2 which in turn activates complex downstream signaling cascades. Activates at least 4 major downstream signaling cascades including the RAS-RAF-MEK-ERK, PI3 kinase-AKT, PLCgamma-PKC and STATs modules (PubMed:27153536). May also activate the NF-kappa-B signaling cascade (PubMed:11116146). Also directly phosphorylates other proteins like RGS16, activating its GTPase activity and probably coupling the EGF receptor signaling to the G protein-coupled receptor signaling (PubMed:11602604). Also phosphorylates MUC1 and increases its interaction with SRC and CTNNB1/beta-catenin (PubMed:11483589). Plays a role in enhancing learning and memory performance .
Related Products / Services
Please note: All products are "FOR RESEARCH USE ONLY AND ARE NOT INTENDED FOR DIAGNOSTIC OR THERAPEUTIC USE"
